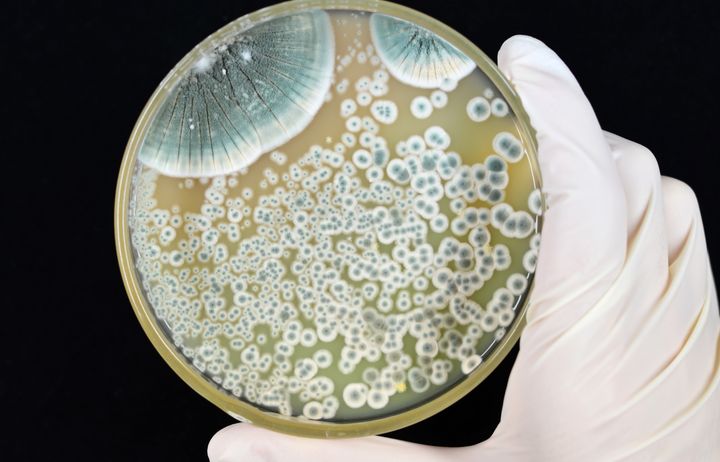

Nora – profile
I was lucky enough to get the opportunity to finish high school at the United World College in Costa Rica before moving to London, where I studied biology in Imperial's Department of Life Sciences. After my 3-year BSc I was accepted onto a Masters course called Genes, Drugs, and Stem Cells: Novel Therapies, this time in the Faculty of Medicine. I then started my PhD in the Gene Therapy Group in the NHLI and should finish later this year!
Interview with Nora
Hear from Nora Clarke, who is studying cell and gene therapy, about why she wanted to work on these topics.
Education
![]() GCSE (or equivalent): Middle Year Diploma Programme – Biology, Chemistry, Physics, English, Dutch, Maths, Computer and Design Technology, Physical Education, Computer Technology, History
GCSE (or equivalent): Middle Year Diploma Programme – Biology, Chemistry, Physics, English, Dutch, Maths, Computer and Design Technology, Physical Education, Computer Technology, History
A-Level (or equivalent): International Baccalaureate – English Literature, Biology, Chemistry, Spanish B, Psychology, Maths
Degrees:
• BSc Biology - Imperial College London
• MSc Genes, Drugs, and Stem Cells: Novel Therapies, Imperial College London
• PhD in Pulmonary Cell and Gene Therapy (ongoing), Imperial College London
Detail about Axel
My research
My research is into treatments for patients with rare lung diseases – I have been developing a technology where we genetically modify macrophages (white blood cells) using a specialised virus and then transplant them into the lung where they can secrete therapeutic proteins.
My inspiration
The lectures on gene therapy in my undergraduate degree caught my attention, and I was lucky enough to join an MSc programme dedicated to novel therapeutic approaches like gene therapy. I quickly realised that 'translational' science research – interventions that will help patients down the road – was what I wanted to do!
Who is your STEM hero?
Jimmy Carter, the former President of the United States. The Carter Centre has been instrumental in almost completely eradicating Guinea-worm disease, largely through distribution of net filters for drinking water, and education about the importance of using them. I love the idea that something as simple as a filter can have had such a profound effect.
Most significant discovery/invention?
The discovery of penicillin by Sir Alexander Fleming. Antibiotics have saved untold lives and dramatically changed the way we live our lives and practice medicine. Antibiotic resistance is one of the largest problems we'll face in the coming years, and we need another equally significant breakthrough to solve it!

Career options after study
I plan on completing a short post-doctoral position before moving into industry to work as a scientist in the pharmaceutical industry, developing cell and gene therapy treatments. Many scientists stay on in academia, and I have colleagues and friends who have moved on to work in sales, patent law, left science for music, and one even works in a gin distillery!

My hobbies
I have been playing hockey regularly since I was 7 years old! I currently captain the ladies 4s at Richmond Hockey club. I also enjoy hot yoga as a great way to clear my mind after a long day in the lab, and borrowing my neighbour's dog for walks!
Nora talks about her research
Nora talks about genes, DNA, genetic diseases, gene therapy and cystic fibrosis.




